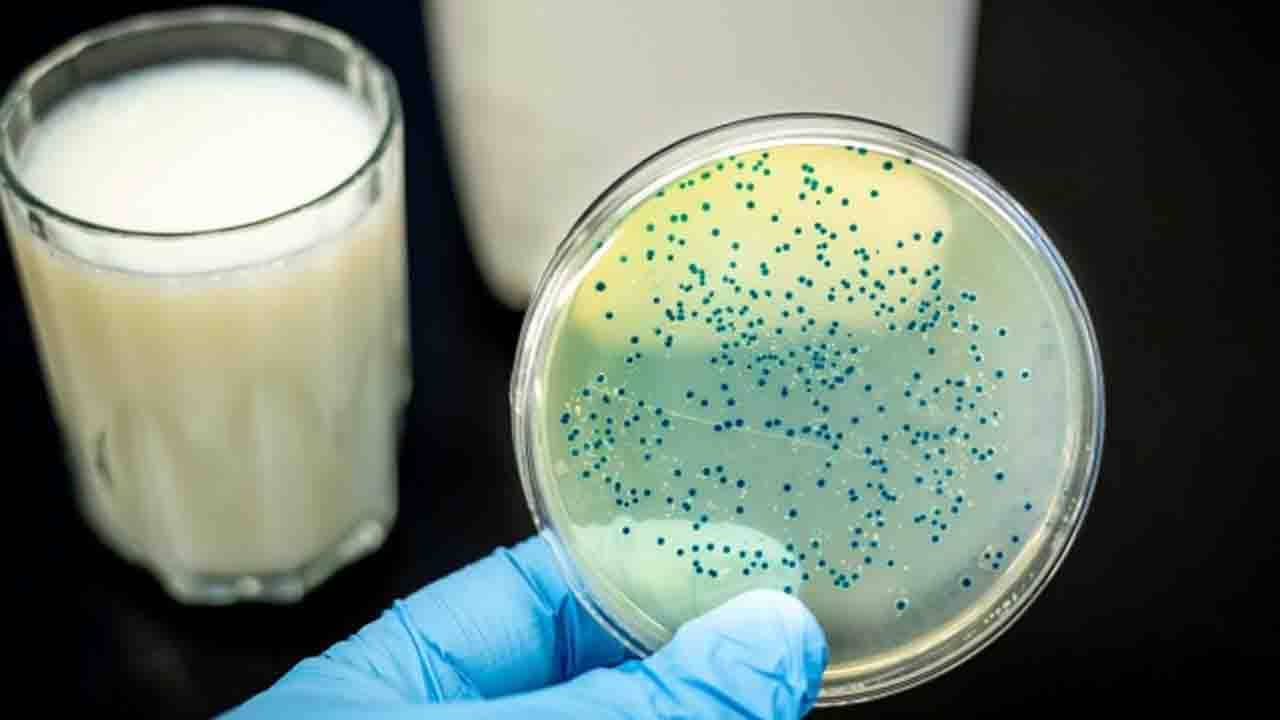

কলকাতা : রাজ্যে ক্রমশ বাড়ছে ব্রুসেলোসিস আক্রান্তের সংখ্যা। একটি বা দুটি নয়, একাধিক জেলায় পরপর ছড়িয়ে পড়েছে সেই রোগ। এবার তাই ১৪টি জেলাকে জরুরি ভিত্তিতে চিকিৎসা পরিকাঠামো তৈরির নির্দেশ দিল স্বাস্থ্য ভবন।
মাস দেড়েক আগে ব্রুসেলোসিসে আক্রান্ত হওয়ার আশঙ্কা নিয়ে স্কুল অব ট্রপিক্যাল মেডিসিনের বহির্বিভাগে এসেছিলেন রাজ্যের বিভিন্ন প্রান্তে কর্মরত বেশ কয়েকজন প্রাণিবন্ধু কর্মী। সেই উদ্বেগকেই কার্যত মান্যতা দিল স্বাস্থ্য দফতর। স্বাস্থ্য ভবন সূত্রে খবর, মালদহ, মুর্শিদাবাদ, নদিয়া, বাঁকুড়া, বিষ্ণুপুর, পশ্চিম বর্ধমান, পূর্ব বর্ধমান, বীরভূম, রামপুরহাট, হুগলি, পূর্ব মেদিনীপুর, দুই ২৪ পরগনা এবং বসিরহাটের স্বাস্থ্য আধিকারিকদের চিঠি দিয়ে জরুরি ভিত্তিতে ব্রুসেলোসিসের চিকিৎসা পরিকাঠামো তৈরি করার নির্দেশ দেওয়া হয়েছে। এই নির্দেশ দিয়েছেন রাজ্যের স্বাস্থ্য অধিকর্তা অজয় চক্রবর্তী।
গত দেড় মাসে শুধু স্কুল অব ট্রপিক্যাল মেডিসিনে ৪৫ জন ব্রুসেলোসিস পজিটিভ হয়েছেন বলে খবর। আর এই সংখ্যাটা নেহাত কম নয়। আক্রান্তের সংখ্যা আরও বাড়তে পারে বলেও অনুমান করছেন বিশেষজ্ঞরা। সে কথা মাথায় রেখেই পরিকাঠামো তৈরির নির্দেশ দেওয়া হয়েছে।
ব্রুসেলা নামক ব্যাকটেরিয়া থেকেই ব্রুসেলোসিস ছড়ায়। এই রোগে মূলত আক্রান্ত হয় গবাদি পশু। সংক্রমিত পশুর দুধ না ফুটিয়ে খেলে, কিংবা তাদের মাংসে হাত দিলে বা পশুপালনের সময় মানুষ এই রোগে আক্রান্ত হতে পারে মানুষ। ব্রুসেলোসিসের প্রাথমিক উপসর্গ করোনার মতোই। কাঁপুনি দিয়ে জ্বর, দুর্বলতা, পেশিতে ব্যথা, শিরদাঁড়ায় ব্যাথা, গাঁটে গাঁটে ব্যথা ও মাথা যন্ত্রণার মতো উপসর্গ দেখা দিতে পারে। প্রথমে রোগ নির্ণয় না হলে পরে ক্রমশ অঙ্গ বিকল হতে থাকে। তার জেরে মৃত্যু পর্যন্ত হতে পারে।
গত নভেম্বরে দেখা গিয়েছে, গবাদি পশুর শরীরে হওয়া এই রোগে আক্রান্ত হচ্ছেন প্রাণিসম্পদ বিকাশ দফতরের কর্মীরা। সাধারণত গবাদি পশুর শরীরে দেখা যায় এই রোগ। এতে গবাদি পশু বন্ধ্যাত্বের শিকার হয়। সেই সব প্রাণিদের জন্য টিকার ব্যবস্থা রয়েছে। অভিযোগ, সেই টিকা দিতে গিয়েই আক্রান্ত হচ্ছেন কর্মীরা। ভ্যাকসিন দিয়ে গিয়ে প্রাণিবন্ধুরা আক্রান্ত হচ্ছেন ব্রুসেলোসিসে। পাশাপাশি রোগাক্রান্ত গবাদি পশু থেকেও রোগ ছড়িয়েছে বলে আশঙ্কা করা হচ্ছে।
আরও পড়ুন : IOCL Fire Update: আতঙ্কের মাঝেই সচল আইওসি, ভয়াবহ অগ্নিকাণ্ডের পর আজ ঘটনাস্থলে মন্ত্রী
ব্রুসেলোসিস সংক্রমণ মূলত দেখা যায় এশিয়া, আফ্রিকা, মধ্যপ্রাচ্য ও দক্ষিণ ও মধ্য আমেরিকার মতো দেশগুলিতে। ভারতে এই রোগের প্রবণতা কম। তবে এ ক্ষেত্রে প্রাণিবন্ধুরা গবাদি পশুদের ভ্যাকসিন দেওয়ার সময় সংক্রমণ ছড়িয়ে পড়ছে বলে মনে তরা হচ্ছে।
আরও পড়ুন : Weather Update: বাড়ল তাপমাত্রা, আগামী কয়েকদিন কেমন থাকবে আবহাওয়া?